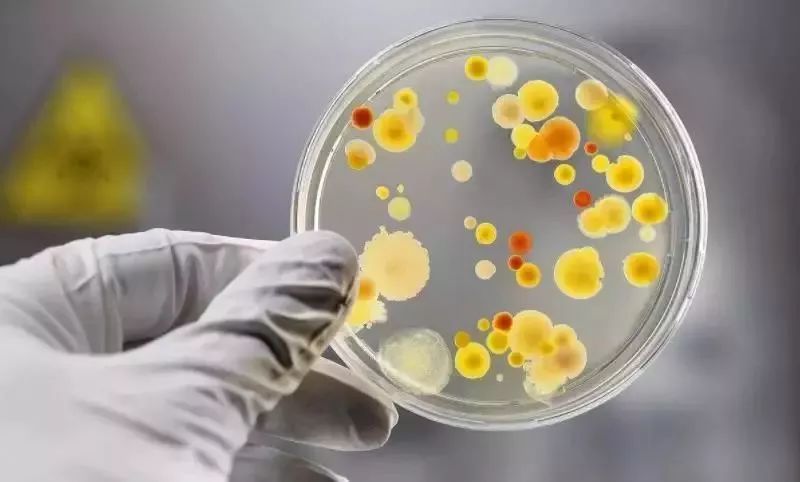
卫生纸可以擦嘴吗？原来这些年都错了

纸巾是家家户户都有的日用必需品,经常大家吃饭完随手就扯一张纸来擦嘴。很多人搞不清楚卫生纸和纸巾纸的区别,两者混用是很常见的事。

也许你会说,这有什么奇怪的?我的生活不需要这么精细。不过,我们想说的是,卫生纸与纸巾纸有很大的区别,一旦用错了,日积月累会影响我们的健康!
标准大不同
我们的生活用纸主要分为两大类:“卫生纸”和“纸巾纸”。
“卫生纸”:日常所用的卫生纸。
“纸巾纸”:包括我们常用的手帕纸、纸巾纸、餐巾纸等等。

许多人认为纸巾纸和卫生纸是一样的,其实他们的差别大着呢,即使都是合格品,国家制定的卫生标准也有很大的不同。
1
含菌量不同
纸巾纸直接接触面部,对卫生要求十分严格,国家规定每克纸巾纸含菌量不得高于200个单位;而卫生纸的要求就相对宽松,每克卫生纸含菌量不高于600个单位就算合格了。
也就是说,卫生纸的含菌量是纸巾纸的三倍。

2
造纸木浆不同
我们买纸巾时看到的原生木浆和纯木浆不是一个概念。
原生木浆是指造纸的木浆都是新原料,根据国家卫生标准,纸巾纸必须使用原生木浆。

纯木浆中允许存在再生材料,用再生材料做卫生纸是符合国家卫生标准的。这样,你会再拿卫生纸擦嘴吗?
3
荧光增白剂要求不同
纸巾纸要与人的面部接触,按规定是必须不含迁移性荧光增白剂的,合格的纸巾纸可以放心使用,不会损伤皮肤。
而卫生标准对于卫生纸是否含有迁移性荧光增白剂,含量多少均没有明确要求,习惯用卫生纸擦脸的朋友要注意了。
用错卫生纸毁了一辈子
如果乱用,尤其是低劣的卫生纸代替餐巾纸对人体的健康会构成潜在的危险。
这里说“潜在”是因为有的人混用并没有感染什么致病菌,但有的人用后身体会马上有所反应,这是因人而异的!但我们绝不能掉以轻心,用自己的健康去做测试。
01
损耗损害神经和血液系统

一些造纸厂用回收纸来生产卫生纸,为了让纸变白、有质感,会在制作的过程中加入大量的滑石粉、柔顺剂、荧光增白剂、漂白助剂等物质。如果经常使用劣质卫生纸擦嘴,很容易把有毒物质擦到嘴上,再吃进肚子里,容易对人的神经系统、血液系统产生损害。
02
导致肝炎痢疾
如果使用废纸做原料,可能还会含有大量细菌、霉菌、真菌等。另外生产中不消毒,更多细菌将会残留,长期使用会引起肠炎、伤寒、痢疾等疾病,有的甚至还可能携带肝炎病菌。
03
引发皮炎过敏

如果经常使用这些劣质卫生纸,不仅可能会导致病从口入,还容易导致皮肤过敏发炎。家中有小孩的要尤其注意。
04
引起呼吸疾病

劣质的卫生纸、餐巾纸中残留增白剂、滑石粉,如果用来擦嘴、擤鼻涕、打喷嚏,很容易导致有害的粉尘进入人体呼吸道,产生呼吸疾病。
05
阴道炎等妇科病
很多女性平时也很注意卫生,但就是莫名其妙的患上了阴道炎,其实这和劣质纸巾、卫生纸有很大关系。女性的阴部本就是一个敏感又脆弱的部位,极容易受到细菌感染。如果使用的劣质卫生纸沾染了细菌,那么对于女性来说,这无疑是为阴道炎症埋下“祸根”。
不同纸巾怎么用?
生活中,我们常见的生活用纸有面巾纸、卫生纸、湿巾纸、厨房用纸等等,每一种的用途都不一样,并不能互相代替。
1
面巾纸:面部专用纸

面巾纸、餐巾纸是专门用来清洁面部的,柔软亲肤,卫生要求最高,用来擦嘴、擦脸更安全。
另外,面巾纸浸湿后韧性较好,不易破碎,擦汗时纸屑不会残留在脸上。
2
卫生纸:厕所专用纸

卫生纸柔软度适中,主要是上厕所时使用的。合格的卫生纸不会对人体造成伤害,虽然卫生标准没有面巾纸高,但量多又便宜。
有些朋友认为自己不差钱,用面巾纸代替卫生纸,这样也是不对的。面巾纸韧性太好,用来代替卫生纸易堵塞马桶,清理起来费时又费力,所以还是要各种纸各司其职!
3
湿巾纸:杀菌专用纸

湿巾纸含有一定杀菌成分,外出不方便洗手时,用湿巾纸就能有效清洁杀菌。
湿巾纸最好不要用来擦脸,面部肌肤比较脆弱,其中的杀菌成分很容易引起瘙痒红肿。
4
厨房用纸:清洁专用纸
厨房用纸有很好的吸水性和吸油性,纸张较大较厚,很适合清洁厨房用具、玻璃窗、镜面、桌子等,是名副其实的清洁小能手。
除了家居清洁,厨房用纸还能清洁食物,烹饪前吸收食材表面水分和油脂,让食材更加新鲜干净。

纸巾怎么选?
一挑:挑合适不挑便宜
纸巾是最常用的生活用品之一,购买的时候要挑满足自己需求的品种,尽量选择可信赖的大品牌。
同类纸巾的价格一般差别不大,一定不要贪小便宜,买一些看起来超便宜的纸,用出了问题可就亏大了。
二看:看包装底部的产品明细
纸巾包装底部一般都有产品明细,要注意看消准字号、产品原材料。消准字号是省级以上的卫生行政部门颁发的才是正规产品,产品原材料尽量选择原生木浆。
三摸:摸手感
好的纸巾摸起来柔软细腻,轻轻揉一揉不会掉毛、掉粉。松散、掉粉的纸巾不管多便宜都不要买。
四闻:闻味道
买纸时要闻一闻,如果有化学药剂的味道,说明用了漂白剂等有害物质,千万别买。选购面巾纸时尽量不要买有香味的,以免擦嘴时香精残留在嘴唇上,一不小心就吃到肚子里了。
这样用纸更安全
01
家中常备多种纸
许多人遇到超市打折就买很多纸巾回家放着,上厕所擦脸清洁都用它,这样就很不科学。各种纸的功能不能相互替代,尽量根据用途选对纸,不要混合着用。
02
1个月内用完
购买时尽量不要购买散装的纸巾,开封后的纸巾最好在1个月内用完。卫生纸和面巾纸要放在纸巾盒里,减少与空气的接触,防止受潮滋生细菌。
03
湿巾不能代替洗手
湿巾纸很方便,但也不能代替洗手,湿巾纸的杀菌成分毕竟是化学药剂,摄入过量了也会对人体有害。如果条件允许,用肥皂、洗手液加上流动的水,才能更好地清洁双手。
04
外出自备纸巾
我们从超市买的面巾纸一般不会有问题,但外面的餐厅可就不一定了,吃个路边摊反被劣质纸巾害了可划不来,用自备的纸巾才更安心。

没想到这纸巾还有这么多学问,
这次全知道了吧!
信息来源:宝山i科普
